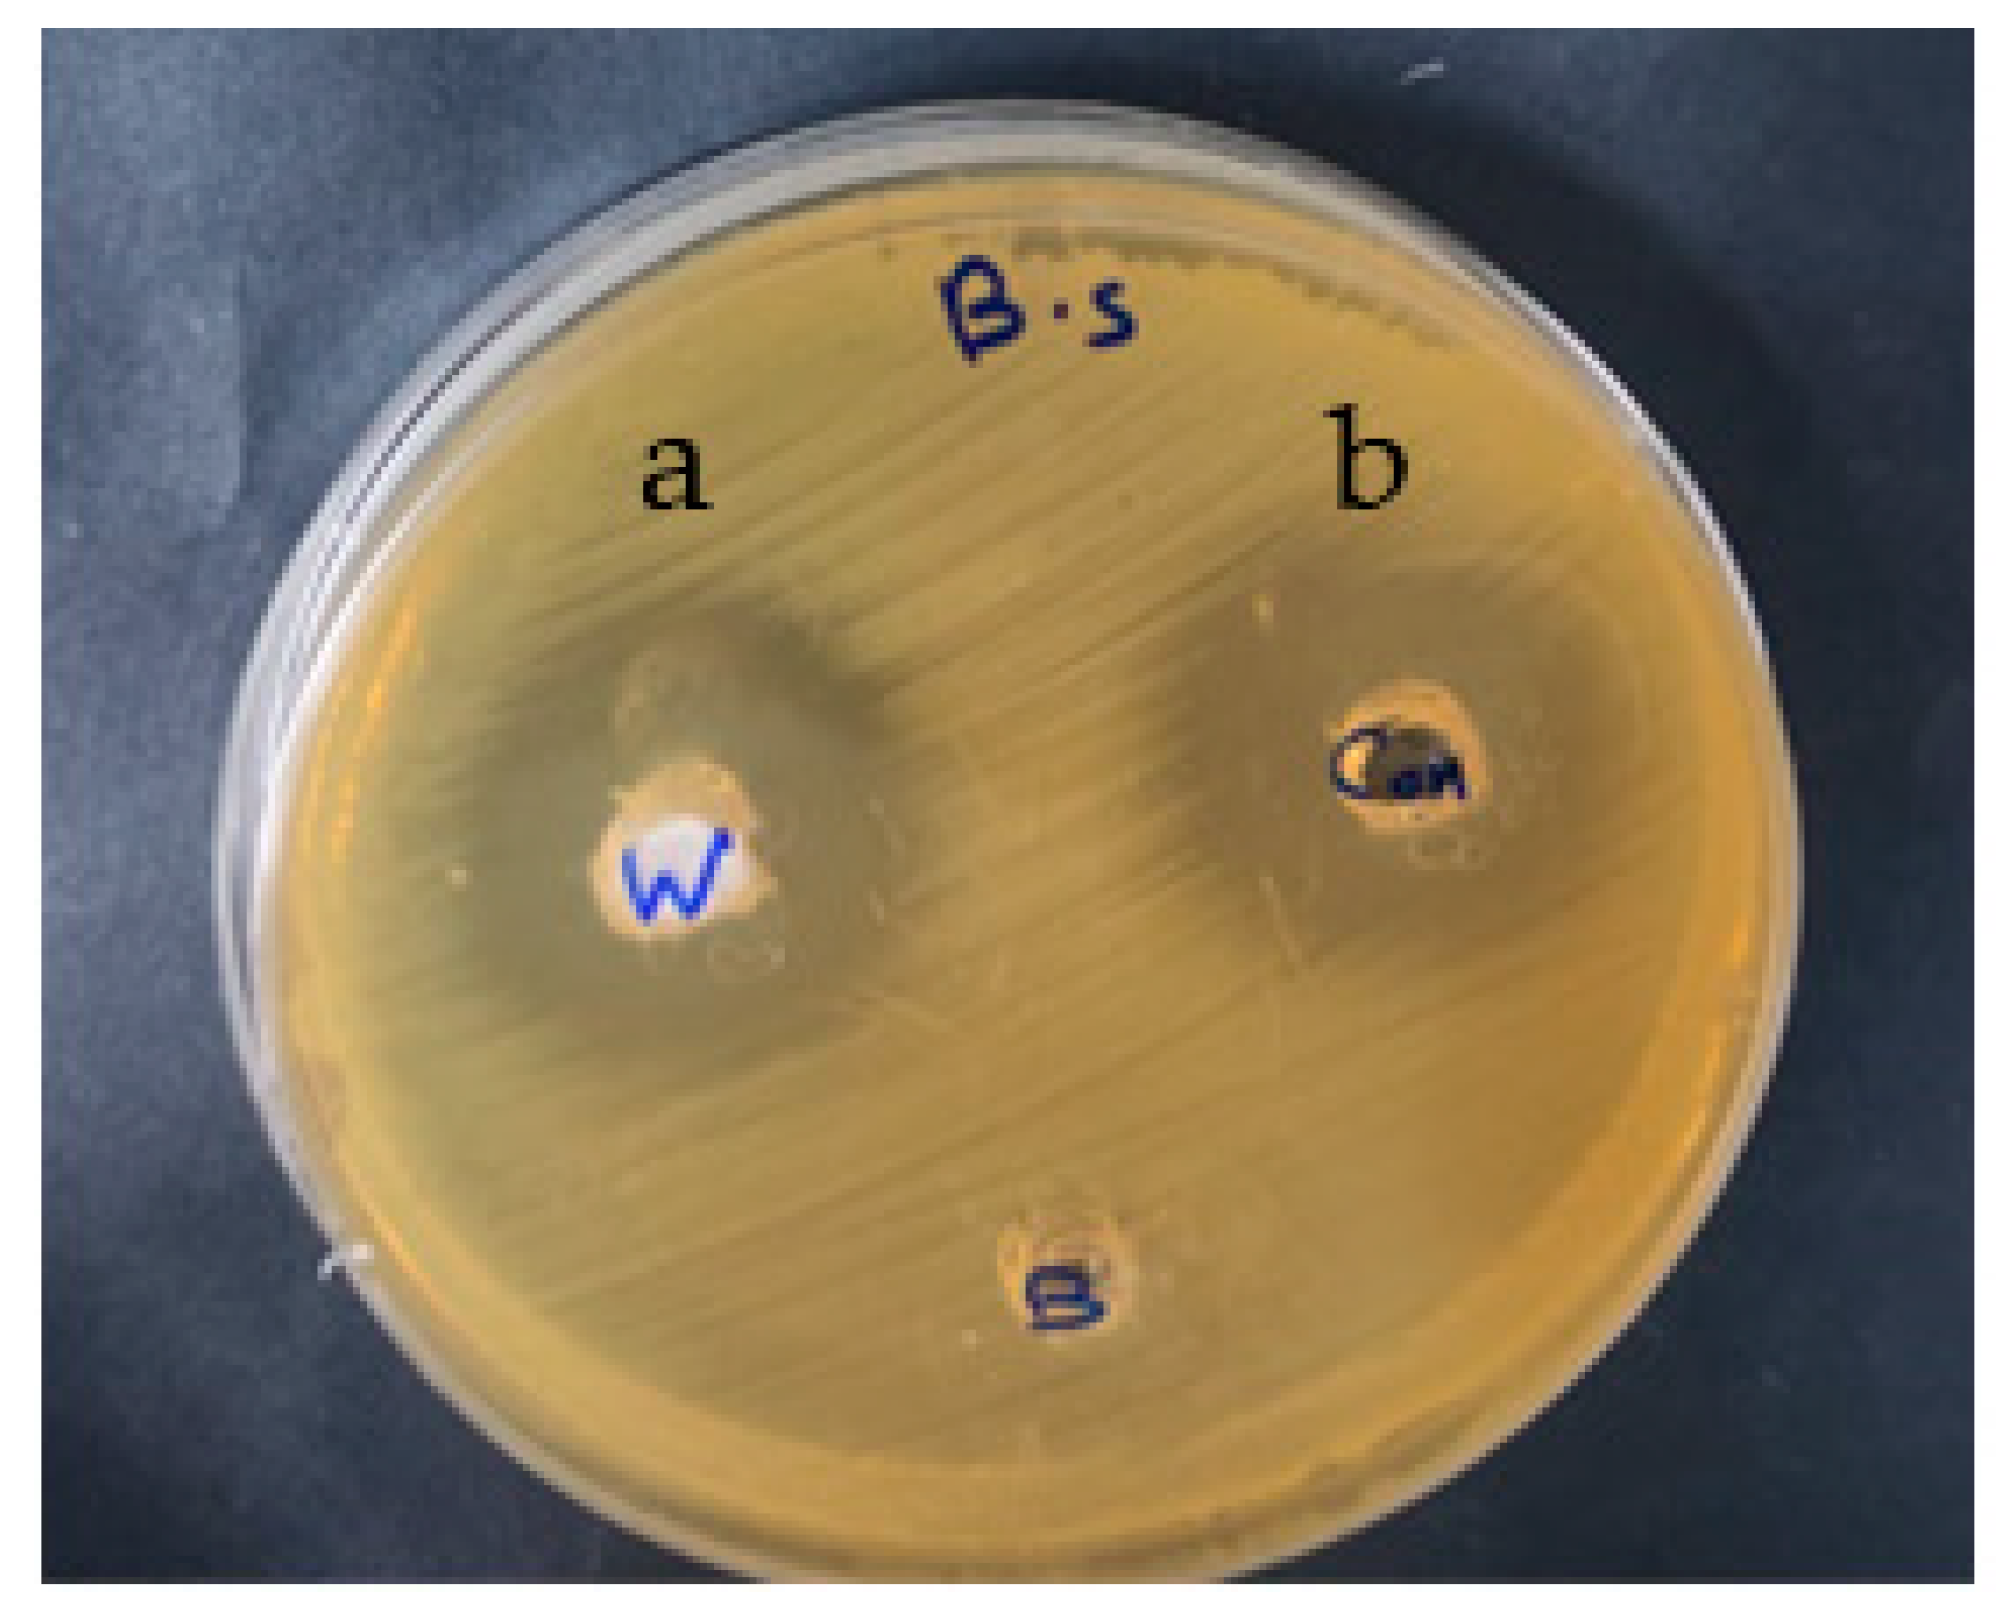
Membranes 12 00408 g005
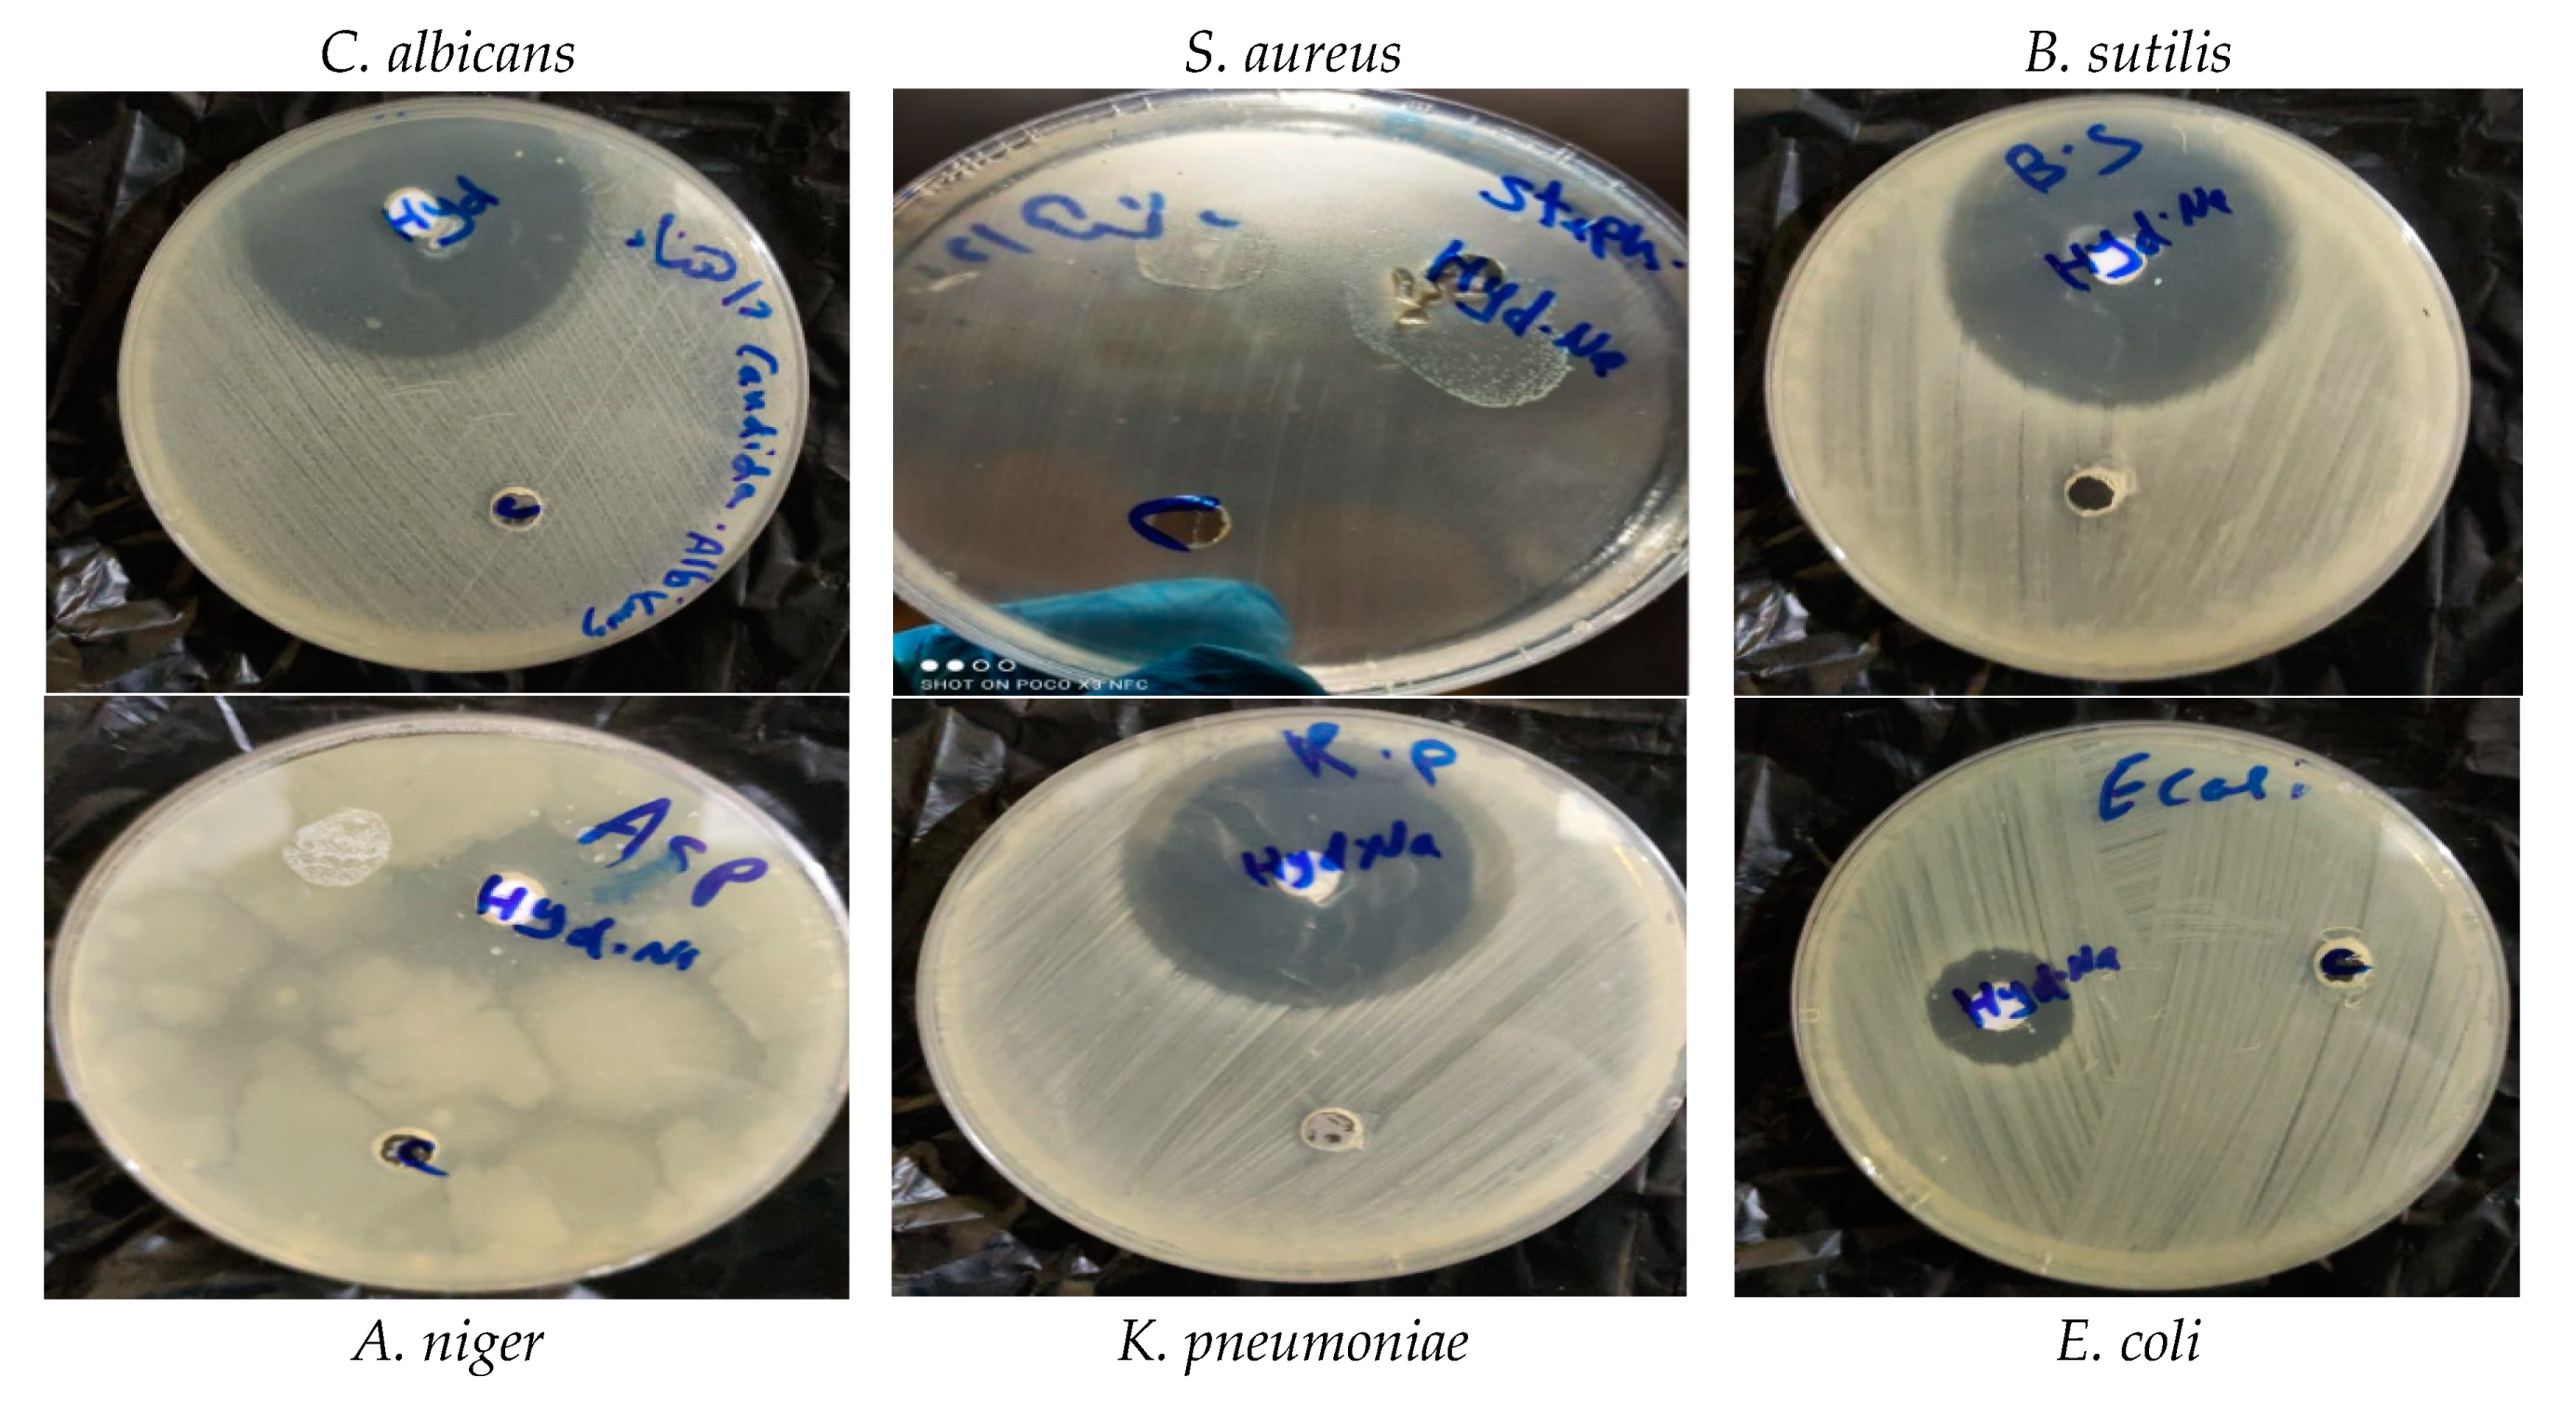
Membranes 12 00408 g006

Synthesis of Natural Nano-Hydroxyapatite from Snail Shells and Its Biological Activity: Antimicrobial, Antibiofilm, and Biocompatibility
Abstract
:1. Introduction
2. Materials and Methods
2.1. Snail Collection
2.2. Identification of Snails
2.3. Preparation of Snail Powder
2.4. Preparation of Hydroxyapatite from Snail
2.5. Physical Characterization
2.5.1. FTIR Spectrum
2.5.2. X-ray Diffraction
2.5.3. Energy Dispersive Analysis of X-ray (EDX)
2.5.4. TEM
2.6. Antimicrobial Activity
2.7. Minimal Inhibitory Concentration (MIC)
2.8. Antibiofilm Activity
2.9. MTT Assay
2.10. Microscopic Studies
2.11. Statistical Analysis
3. Results
3.1. Identification of the Snail
3.2. Characterization of Snail Shell Powder and HAn
3.2.1. FT-IR Analysis
3.2.2. XRD Analysis
3.2.3. Energy Dispersive X-ray (EDX) Analysis
3.2.4. TEM
3.3. Antimicrobial Activity of Atactodea glabrata Snail Shell
3.4. Antimicrobial of HAn
3.5. MIC of HA
3.6. Biofilm Formation Effects of HAn
3.7. MTT Assay
4. Conclusions
Author Contributions
Funding
Institutional Review Board Statement
Informed Consent Statement
Data Availability Statement
Acknowledgments
Conflicts of Interest
References
- Landecker, H. Antibiotic Resistance and the Biology of History. Body Soc. 2016, 22, 19–52. [Google Scholar] [CrossRef] [PubMed] [Green Version]
- Høiby, N.; Bjarnsholt, T.; Givskov, M.; Molin, S.; Ciofu, O. Antibiotic resistance of bacterial biofilms. Int. J. Antimicrob. Agents 2010, 35, 322–332. [Google Scholar] [CrossRef] [PubMed] [Green Version]
- Stewart, P.S. Mechanisms of antibiotic resistance in bacterial biofilms. Int. J. Med. Microbiol. 2002, 292, 107–113. [Google Scholar] [CrossRef] [PubMed]
- Singh, S.; Singh, S.K.; Chowdhury, I.; Singh, R. Understanding the Mechanism of Bacterial Biofilms Resistance to Antimicrobial Agents. Open Microbiol. J. 2017, 11, 53–62. [Google Scholar] [CrossRef] [PubMed] [Green Version]
- Fulaz, S.; Vitale, S.; Quinn, L.; Casey, E. Nanoparticle–Biofilm Interactions: The Role of the EPS Matrix. Trends Microbiol. 2019, 27, 915–926. [Google Scholar] [CrossRef]
- Baidamshina, D.R.; Trizna, E.Y.; Holyavka, M.G.; Bogachev, M.I.; Artyukhov, V.G.; Akhatova, F.S.; Rozhina, E.V.; Fakhrullin, R.F.; Kayumov, A.R. Targeting microbial biofilms using Ficin, a nonspecific plant protease. Sci. Rep. 2017, 7, srep46068. [Google Scholar] [CrossRef] [Green Version]
- Žiemytė, M.; Rodríguez-Díaz, J.C.; Ventero, M.P.; Mira, A.; Ferrer, M.D. Effect of Dalbavancin on Staphylococcal Biofilms When Administered Alone or in Combination With Biofilm-Detaching Compounds. Front. Microbiol. 2020, 11, 553. [Google Scholar] [CrossRef] [Green Version]
- Baidamshina, D.R.; Koroleva, V.A.; Trizna, E.Y.; Pankova, S.M.; Agafonova, M.N.; Chirkova, M.N.; Vasileva, O.S.; Akhmetov, N.; Shubina, V.V.; Porfiryev, A.G.; et al. Anti-biofilm and wound-healing activity of chitosan-immobilized Ficin. Int. J. Biol. Macromol. 2020, 164, 4205–4217. [Google Scholar] [CrossRef]
- Sami, R.; Khojah, E.; Elhakem, A.; Benajiba, N.; Helal, M.; Alhuthal, N.; Alzahrani, S.A.; Alharbi, M.; Chavali, M. Performance Study of Nano/SiO2 Films and the Antimicrobial Application on Cantaloupe Fruit Shelf-Life. Appl. Sci. 2021, 11, 3879. [Google Scholar] [CrossRef]
- Morris, J.P.; Backeljau, T.; Chapelle, G. Shells from aquaculture: A valuable biomaterial, not a nuisance waste product. Rev. Aquac. 2019, 11, 42–57. [Google Scholar] [CrossRef] [Green Version]
- Hart, A. Mini-review of waste shell-derived materials’ applications. Waste Manag. Res. 2020, 38, 514–527. [Google Scholar] [CrossRef] [PubMed]
- Jatto, E.O.; Asia, I.O.; Egbon, E.E.; Otutu, J.O.; Chukwuedo, M.E.; Ewansiha, C.J. Treatment Of Waste Water From Food Industry Using Snail Shell. Acaedmia Arena 2010, 2, 32–36. [Google Scholar]
- Magnabosco, G.; Giuri, D.; Di Bisceglie, A.P.; Scarpino, F.; Fermani, S.; Tomasini, C.; Falini, G. New material perspective for waste seashells by covalent functionalization. ACS Sustain. Chem. Eng. 2021, 9, 6203–6208. [Google Scholar] [CrossRef]
- Ummartyotin, S.; Manuspiya, H. Eggshell waste: An effective source of hydroxyapatite for photocatalyst. J. Met. Mater. Miner. 2018, 28, 124–135. [Google Scholar]
- Goloshchapov, D.L.; Kashkarov, V.M.; Rumyantseva, N.A.; Seredin, P.V.; Lenshin, A.S.; Agapov, B.L.; Domashevskaya, E.P. Synthesis of nanocrystalline hydroxyapatite by precipitation using hen’s eggshell. Ceram. Int. 2013, 39, 4539–4549. [Google Scholar] [CrossRef]
- Ramesh, S.; Loo, Z.Z.; Tan, C.Y.; Chew, W.J.K.; Ching, Y.C.; Tarlochan, F.; Chandran, H.; Krishnasamy, S.; Bang, L.T.; Sarhan, A.A.D. Characterization of biogenic hydroxyapatite derived from animal bones for biomedical applications. Ceram. Int. 2018, 44, 10525–10530. [Google Scholar] [CrossRef]
- Trinkunaite-Felsen, J.; Prichodko, A.; Semasko, M.; Skaudzius, R.; Beganskiene, A.; Kareiva, A. Synthesis and characterization of iron-doped/substituted calcium hydroxyapatite from seashells Macoma balthica (L.). Adv. Powder Technol. 2015, 26, 1287–1293. [Google Scholar] [CrossRef]
- Mohd Pu’ad, N.A.S.; Koshy, P.; Abdullah, H.Z.; Idris, M.I.; Lee, T.C. Syntheses of hydroxyapatite from natural sources. Heliyon 2019, 5, e01588. [Google Scholar] [CrossRef] [Green Version]
- Akram, M.; Ahmed, R.; Shakir, I.; Ibrahim, W.A.W.; Hussain, R. Extracting hydroxyapatite and its precursors from natural resources. J. Mater. Sci. 2014, 49, 1461–1475. [Google Scholar] [CrossRef]
- Dorozhkin, S.V. Calcium orthophosphates Occurrence, properties, biomineralization, pathological calcification and biomimetic applications. Biomatter 2011, 1, 121–164. [Google Scholar] [CrossRef]
- Rafeek, A.D.; Choi, G.; Evans, L.A. Controlled synthesis of dicalcium phosphate dihydrate (DCPD) from metastable solutions: Insights into pathogenic calcification. J. Mater. Sci. Mater. Med. 2021, 32, 142. [Google Scholar] [CrossRef]
- Cai, B.; Jiang, N.; Zhang, L.; Huang, J.; Wang, D.; Li, Y. Bioactive and Compatible Polymers Nano-hydroxyapatite/polyamide66 composite scaffold conducting osteogenesis to repair mandible defect. J. Bioact. Compat. Polym. 2019, 34, 72–82. [Google Scholar] [CrossRef]
- Kensche, A.; Holder, C.; Basche, S.; Tahan, N.; Hannig, C.; Hannig, M. Efficacy of a mouthrinse based on hydroxyapatite to reduce initial bacterial colonisation in situ. Arch. Oral Biol. 2017, 80, 18–26. [Google Scholar] [CrossRef]
- De Carvalho, F.G.; Vieira, B.R.; Santos, R.L.D.; Carlo, H.L.; Lopes, P.Q.; de Lima, B.A.S.G. In vitro effects of nano-hydroxyapatite paste on initial enamel carious lesions. Pediatr. Dent. 2014, 36, 85–89. [Google Scholar] [PubMed]
- Dorozhkin, S.V. Dental Applications of Calcium Orthophosphates (CaPO4). J. Dent. Res. 2019, 1, 1007. [Google Scholar]
- Sodagar, A.; Akhavan, A.; Hashemi, E.; Arab, S.; Pourhajibagher, M.; Sodagar, K.; Kharrazifard, M.J.; Bahador, A. Evaluation of the antibacterial activity of a conventional orthodontic composite containing silver/hydroxyapatite nanoparticles. Prog. Orthod. 2016, 17, 40. [Google Scholar] [CrossRef] [PubMed] [Green Version]
- Vimala, P.; Thilaga, R.D. Antibacterial Activity of the Crude Extract of a Gastropod Lambis lambis from the Tuticorin Coast, India. World Appl. Sci. J. 2012, 16, 1334–1337. [Google Scholar]
- Croteau, M.N.; Luoma, S.N.; Stewart, A.R. Trophic transfer of metals along freshwater food webs: Evidence of cadmium biomagnification in nature. Limnol. Oceanogr. 2005, 50, 1511–1519. [Google Scholar] [CrossRef] [Green Version]
- Gergely, G.; Wéber, F.; Lukács, I.; Illés, L.; Tóth, A.L.; Horváth, Z.E.; Mihály, J.; Balázsi, C. Nano-hydroxyapatite preparation from biogenic raw materials. Cent. Eur. J. Chem. 2010, 8, 375–381. [Google Scholar] [CrossRef]
- Khiri, M.Z.A.; Matori, K.A.; Zainuddin, N.; Abdullah, C.A.C.; Alassan, Z.N.; Baharuddin, N.F.; Zaid, M.H.M. The usability of ark clam shell (Anadara granosa) as calcium precursor to produce hydroxyapatite nanoparticle via wet chemical precipitate method in various sintering temperature. Springerplus 2016, 5, 1206. [Google Scholar] [CrossRef] [Green Version]
- Nancollas, G.H.; Wu, W.; Tang, R. The Control of Mineralization on Natural and Implant Surfaces. MRS Online Proc. Libr. 1999, 599, 99–108. [Google Scholar] [CrossRef]
- Zhou, Y.; Teng, F.; Tian, T.; Sami, R.; Wu, C.; Zhu, Y.; Zheng, L.; Jiang, L.; Wang, Z.; Li, Y. The impact of soy protein isolate-dextran conjugation on capsicum oleoresin (Capsicum annuum L.) nanoemulsions. Food Hydrocoll. 2020, 108, 105818. [Google Scholar] [CrossRef]
- And Bhimba, D. Anticancer Activity of Silver Nanoparticles Synthesized by the Seaweed Ulva lactuca Invitro. Sci. Rep. 2012, 1, 242. [Google Scholar] [CrossRef]
- Jain, N.; Bhargava, A.; Majumdar, S.; Tarafdar, J.C.; Panwar, J. Extracellular biosynthesis and characterization of silver nanoparticles using Aspergillus flavus NJP08: A mechanism perspective. Nanoscale 2011, 3, 635–641. [Google Scholar] [CrossRef]
- Smania, J.A.; Monache, F.D.; Smania, E.D.F.A.; Cuneo, R.S. Antibacterial Activity of Steroidal Compounds Isolated from Ganoderma applanatum (Pers.) Pat. (Aphyllophoromycetideae) Fruit Body. Int. J. Med. Mushrooms 1999, 1, 325–330. [Google Scholar] [CrossRef]
- Chen, H.; Zhong, Q. Lactobionic acid enhances the synergistic effect of nisin and thymol against Listeria monocytogenes Scott A in tryptic soy broth and milk. Int. J. Food Microbiol. 2017, 260, 36–41. [Google Scholar] [CrossRef]
- Tang, J.N.; Kang, M.S.; Chen, H.C.; Shi, X.M.; Zhou, R.; Chen, J.; Du, Y.W. The staphylococcal nuclease prevents biofilm formation in Staphylococcus aureus and other biofilm-forming bacteria. Sci. China Life Sci. 2011, 54, 863–869. [Google Scholar] [CrossRef] [Green Version]
- Farag, M.M.; Abd-Allah, W.M.; Ahmed, H.Y.A. Study of the dual effect of gamma irradiation and strontium substitution on bioactivity, cytotoxicity, and antimicrobial properties of 45S5 bioglass. J. Biomed. Mater. Res. Part A 2017, 105, 1646–1655. [Google Scholar] [CrossRef]
- Kumar, G.S.; Sathish, L.; Govindan, R.; Girija, E.K. Utilization of snail shells to synthesise hydroxyapatite nanorods for orthopedic applications. RSC Adv. 2015, 5, 39544–39548. [Google Scholar] [CrossRef]
- Mohonta, S.K.; Maria, K.H.; Rahman, S.; Das, H.; Hoque, S.M. Synthesis of hydroxyapatite nanoparticle and role of its size in hydroxyapatite/chitosan–gelatin biocomposite for bone grafting. Int. Nano Lett. 2021, 11, 381–393. [Google Scholar] [CrossRef]
- Berzina-Cimdina, L.; Borodajenko, N. Research of Calcium Phosphates Using Fourier Transform Infrared Spectroscopy. In Infrared Spectroscopy—Materials Science, Engineering and Technology; Theophile, T., Ed.; InTech: Rijeka, Croatia, 2012. [Google Scholar] [CrossRef] [Green Version]
- Sudarsanan, K.; Young, R.A. Significant precision in crystal structural details. Holly Springs hydroxyapatite. Acta Crystallogr. Sect. B Struct. Crystallogr. Cryst. Chem. 1969, 25, 1534–1543. [Google Scholar] [CrossRef]
- Rincón-López, J.A.; Hermann-Muñoz, J.A.; Giraldo-Betancur, A.L.; De Vizcaya-Ruiz, A.; Alvarado-Orozco, J.M.; Muñoz-Saldaña, J. Synthesis, characterization and in vitro study of synthetic and bovine-derived hydroxyapatite ceramics: A comparison. Materials 2018, 9, 333. [Google Scholar] [CrossRef] [PubMed] [Green Version]
- Dorozhkin, S.V. Biocomposites and hybrid biomaterials based on calcium orthophosphates. Biomatter 2011, 1, 3–56. [Google Scholar] [CrossRef] [PubMed] [Green Version]
- Dorozhkin, S.V. Calcium orthophosphate coatings, films and layers. Prog. Biomater. 2012, 1, 1. [Google Scholar] [CrossRef] [PubMed] [Green Version]
- Dorozhkin, S.V. Functionalized calcium orthophosphates (CaPO4) and their biomedical applications. J. Mater. Chem. B 2019, 7, 7471. [Google Scholar] [CrossRef] [PubMed]
- Chaari, K.; Ben Ayed, F.; Bouaziz, J.; Bouzouita, K. Elaboration and characterization of fluorapatite ceramic with controlled porosity. Mater. Chem. Phys. 2009, 113, 219–226. [Google Scholar] [CrossRef]
- Sallemi, I.; Ben Ayed, F.; Bouaziz, J. Effect of fluorapatite additive on the mechanical properties of tricalcium phosphate-zirconia composites. IOP Conf. Ser. Mater. Sci. Eng. 2012, 28, 012029. [Google Scholar] [CrossRef] [Green Version]
- Watanabe, Y.; Moriyoshi, Y.; Suetsugu, Y.; Ikoma, T.; Kasama, T.; Hashimoto, T.; Yamada, H.; Tanaka, J. Hydrothermal Formation of Hydroxyapatite Layers on the Surface of Type-A Zeolite. J. Am. Ceram. Soc. 2004, 87, 1395–1397. [Google Scholar] [CrossRef]
- Prabakaran, K.; Balamurugan, A.; Rajeswari, S. Development of calcium phosphate based apatite from hen’s eggshell. Bull. Mater. Sci. 2005, 28, 115–119. [Google Scholar] [CrossRef] [Green Version]
- Osseni, S.; Bonou, S.; Sagbo, E.; Ahouansou, R.; Neumeyer, D.; Verelst, M.; Mauricot, R.; Osseni, S.; Bonou, S.; Sagbo, E.; et al. Synthesis of Calcium Phosphate Bioceramics Based on Snail Shells: Towards a Valorization of Snail Shells from Republic of Benin. Am. J. Chem. 2018, 8, 90–95. [Google Scholar] [CrossRef]
- Ademolu, K.O.; Akintola, M.Y.; Olalonye, A.O.; Adelabu, B.A. Traditional utilization and biochemical composition of six mollusc shells in Nigeria. Rev. Biol. Trop. 2015, 63, 459–464. [Google Scholar] [CrossRef] [Green Version]
- Besinis, A.; Van Noort, R.; Martin, N. Infiltration of demineralized dentin with silica and hydroxyapatite nanoparticles. Dent. Mater. 2012, 28, 1012–1023. [Google Scholar] [CrossRef] [PubMed]
- Chen, H.; Clarkson, B.H.; Sun, K.; Mansfield, J.F. Self-assembly of synthetic hydroxyapatite nanorods into an enamel prism-like structure. J. Colloid Interface Sci. 2005, 288, 97–103. [Google Scholar] [CrossRef] [PubMed]
- Abiona, J.A.; Akinduti, A.; Osinowo, O.A.; Onagbesan, O.M. Comparative evaluation of inhibitory activity of Epiphgram from albino and normal skinned giant African land snail (Archachatina marginata) against selected bacteria isolates. Ethiop. J. Environ. Stud. Manag. 2013, 6, 177–181. [Google Scholar] [CrossRef] [Green Version]
- Alhussary, B.N.; Taqa, G.A.; Taqa, A.A.A. Preparation and Characterization of Natural Nano Hydroxyapatite From Eggshell and Seashell and Its Effect on Bone Healing. J. Appl. Vet. Sci. 2020, 5, 25–32. [Google Scholar] [CrossRef] [Green Version]
- Sami, R.; Soltane, S.; Helal, M. membranes Microscopic Image Segmentation and Morphological Characterization of Novel Chitosan/Silica Nanoparticle/Nisin Films Using Antimicrobial Technique for Blueberry Preservation. Membranes 2021, 11, 303. [Google Scholar] [CrossRef]
- Shikinami, Y.; Okuno, M. Bioresorbable devices made of forged composites of hydroxyapatite (HA) particles and poly-L-lactide (PLLA): Part I. Basic characteristics. Biomaterials 1999, 20, 859–877. [Google Scholar] [CrossRef]
- Zhou, H.; Lawrence, J.G.; Bhaduri, S.B. Fabrication aspects of PLA-CaP/PLGA-CaP composites for orthopedic applications: A review. Acta Biomater. 2012, 8, 1999–2016. [Google Scholar] [CrossRef]
- Zarnowski, R.; Westler, W.M.; Lacmbouh, G.A.; Marita, J.M.; Bothe, J.R.; Bernhardt, J.; Sahraoui, A.L.H.; Fontainei, J.; Sanchez, H.; Hatfeld, R.D.; et al. Novel entries in a fungal biofilm matrix encyclopedia. mBio 2014, 5, e01333-14. [Google Scholar] [CrossRef] [Green Version]
- Olivares, E.; Badel-Berchoux, S.; Provot, C.; Prévost, G.; Bernardi, T.; Jehl, F. Clinical Impact of Antibiotics for the Treatment of Pseudomonas aeruginosa Biofilm Infections. Front. Microbiol. 2020, 10, 2894. [Google Scholar] [CrossRef]
- Brescó, M.S.; Harris, L.G.; Thompson, K.; Stanic, B.; Morgenstern, M.; O’Mahony, L.; Richards, R.G.; Moriarty, T.F. Pathogenic mechanisms and host interactions in Staphylococcus epidermidis device-related infection. Front. Microbiol 2017, 8, 1401. [Google Scholar] [CrossRef] [PubMed] [Green Version]
- Cavalcanti, I.M.G.; Nobbs, A.H.; Ricomini-Filho, A.P.; Jenkinson, H.F.; Del Bel Cury, A.A. Interkingdom cooperation between Candida albicans, Streptococcus oralis and Actinomyces oris modulates early biofilm development on denture material. Pathog. Dis. 2016, 74, 2. [Google Scholar] [CrossRef] [Green Version]
- Moormeier, D.E.; Bayles, K.W. Staphylococcus aureus biofilm: A complex developmental organism. Mol. Microbiol. 2017, 104, 365–376. [Google Scholar] [CrossRef] [PubMed] [Green Version]
- Fàbrega, A.; Soto, S.M.; Ballesté-Delpierre, C.; Fernández-Orth, D.; Jiménez de Anta, M.T.; Vila, J. Impact of quinolone-resistance acquisition on biofilm production and fitness in Salmonella enterica. J. Antimicrob. Chemother. 2014, 69, 1815–1824. [Google Scholar] [CrossRef] [Green Version]
- Koo, H.; Allan, R.N.; Howlin, R.P.; Stoodley, P.; Hall-Stoodley, L. Targeting microbial biofilms: Current and prospective therapeutic strategies. Nat. Rev. Microbiol. 2017, 15, 740–755. [Google Scholar] [CrossRef]
- Cavalheiro, M.; Teixeira, M.C. Candida Biofilms: Threats, challenges, and promising strategies. Front. Med. 2018, 5, 28. [Google Scholar] [CrossRef] [Green Version]
- Abdelraof, M.; Hasanin, M.S.; Farag, M.M.; Ahmed, H.Y. Green synthesis of bacterial cellulose/bioactive glass nanocomposites: Effect of glass nanoparticles on cellulose yield, biocompatibility and antimicrobial activity. Int. J. Biol. Macromol. 2019, 138, 975–985. [Google Scholar] [CrossRef]
- Hench, L.L.; Polak, J.M. Third-Generation Biomedical Materials. Science 2002, 295, 1014–1017. [Google Scholar] [CrossRef] [Green Version]
- Youssef, M.; Korin, A.; Zhan, F.; Hady, E.; Ahmed, H.Y.; Geng, F.; Chen, Y.; Li, B. Encapsulation of Lactobacillus Salivarius in Single and Dual Biopolymer. J. Food Eng. 2020, 294, 110398. [Google Scholar] [CrossRef]
- Goldberg, M.A.; Krohicheva, P.A.; Fomin, A.S.; Khairutdinova, D.R.; Antonova, O.S.; Baikin, A.S.; Smirnov, V.V.; Fomina, A.A.; Leonov, A.V.; Mikheev, I.V.; et al. In situ magnesium calcium phosphate cements formation: From one pot powders precursors synthesis to in vitro investigations. Bioact. Mater. 2020, 5, 644–658. [Google Scholar] [CrossRef]
- Day, E.S.; Osborn, L.; Whitty, A. Effect of Divalent Cations on the Affinity and Selectivity of α4 Integrins Towards the Integrin Ligands Vascular Cell Adhesion Molecule-1 and Mucosal Addressin Cell Adhesion Molecule-1: Ca 2+ Activation of Integrin α4β1 Confers a Distinct Ligand Specifici. Cell Commun. Adhes. 2009, 9, 205–219. [Google Scholar] [CrossRef] [PubMed] [Green Version]
- Numata, T.; Okada, Y. Molecular determinants of sensitivity and conductivity of human TRPM7 to Mg2+ and Ca2+. Channels 2008, 2, 283–286. [Google Scholar] [CrossRef] [PubMed] [Green Version]
- Farag, M.M.; Al-Rashidy, Z.M.; Ahmed, M.M. In vitro drug release behavior of Ce-doped nano-bioactive glass carriers under oxidative stress. Mater. Sci. Mater. Med. 2019, 30, 18. [Google Scholar] [CrossRef] [PubMed]
- Kim, H.W.; Knowles, J.C.; Kim, H.E. Hydroxyapatite and gelatin composite foams processed via novel freeze-drying and crosslinking for use as temporary hard tissue scaffolds. J. Biomed. Mater. Res. Part A 2005, 72, 136–145. [Google Scholar] [CrossRef]

| Element (%) | Snail Shell Atactodea glabrata | HAn Atactodea glabrata |
|---|---|---|
| Ca | 35.54 | 24.53 |
| P | 0.01 | 20.67 |
| O | 61.24 | 48.48 |
| Tested Organisms | Inhibition Zone Diameter (mm) | |
|---|---|---|
| Snail Shell (Atactodea glabrata) | Standard | |
| Gram-positive bacteria | Gentamicin | |
| Staphylococcus aureus (ATCC 538) | 20 ± 0.06 | 22 ± 0.03 |
| Bacillus subtilis (ATCC 6633) | 32 ± 0.12 | 26 ± 0.09 |
| Gram-negative bacteria | Gentamicin | |
| Klebsiella pneumoniae (ATCC 13883) | No activity | 25 ± 0.15 |
| Escherichia coli (ATCC 8739) | 26 ± 0.07 | 30 ± 0.16 |
| Fungi | Amphotericin B | |
| Candida albicans (ATCC 10221) | 17 ± 0.04 | 21 ± 0.06 |
| Aspergillus niger | No activity | 15 ± 0.08 |
| Tested Organisms | Inhibition Zone Diameter (mm) | |
|---|---|---|
| HAn | Standard | |
| Gram-positive bacteria | Gentamicin | |
| Staphylococcus aureus (ATCC 6538) | 30 ± 0.03 | 22 ± 0.03 |
| Bacillus subtilis (ATCC 6633) | 43 ±0.05 | 26 ± 0.09 |
| Gram-negative bacteria | Gentamicin | |
| Klebsiella pneumoniae (ATCC 13883) | 42 ± 0.14 | 25 ± 0.15 |
| Escherichia coli (ATCC 8739) | 19 ± 0.18 | 30 ± 0.16 |
| Fungi | Amphotericin B | |
| Candida albicans (ATCC 10221) | 44 ± 0.07 | 21 ± 0.06 |
| Aspergillus niger | 22 ± 0.19 | 15 ± 0.08 |
| Pathogenic Microorganism | HAn |
|---|---|
| Staphylococcus aureus (ATCC 6538) | 7.8 ± 1.24 |
| Escherichia coli (ATCC 8739) | 25 ± 0.85 |
| Bacillus sutilis (ATCC 6633) | 0.97 ± 1.35 |
| Klebsiella pneumoniae (ATCC 13883) | 3.9 ± 1.46 |
| Candida albicans (ATCC 10221) | 0.97 ± 0.76 |
Publisher’s Note: MDPI stays neutral with regard to jurisdictional claims in published maps and institutional affiliations. |
© 2022 by the authors. Licensee MDPI, Basel, Switzerland. This article is an open access article distributed under the terms and conditions of the Creative Commons Attribution (CC BY) license (https://creativecommons.org/licenses/by/4.0/).
Share and Cite
Ahmed, H.Y.; Safwat, N.; Shehata, R.; Althubaiti, E.H.; Kareem, S.; Atef, A.; Qari, S.H.; Aljahani, A.H.; Al-Meshal, A.S.; Youssef, M.; et al. Synthesis of Natural Nano-Hydroxyapatite from Snail Shells and Its Biological Activity: Antimicrobial, Antibiofilm, and Biocompatibility. Membranes 2022, 12, 408. https://doi.org/10.3390/membranes12040408
Ahmed HY, Safwat N, Shehata R, Althubaiti EH, Kareem S, Atef A, Qari SH, Aljahani AH, Al-Meshal AS, Youssef M, et al. Synthesis of Natural Nano-Hydroxyapatite from Snail Shells and Its Biological Activity: Antimicrobial, Antibiofilm, and Biocompatibility. Membranes. 2022; 12(4):408. https://doi.org/10.3390/membranes12040408
Chicago/Turabian StyleAhmed, Hanaa Y., Nesreen Safwat, Reda Shehata, Eman Hillal Althubaiti, Sayed Kareem, Ahmed Atef, Sameer H. Qari, Amani H. Aljahani, Areej Suliman Al-Meshal, Mahmoud Youssef, and et al. 2022. "Synthesis of Natural Nano-Hydroxyapatite from Snail Shells and Its Biological Activity: Antimicrobial, Antibiofilm, and Biocompatibility" Membranes 12, no. 4: 408. https://doi.org/10.3390/membranes12040408
APA StyleAhmed, H. Y., Safwat, N., Shehata, R., Althubaiti, E. H., Kareem, S., Atef, A., Qari, S. H., Aljahani, A. H., Al-Meshal, A. S., Youssef, M., & Sami, R. (2022). Synthesis of Natural Nano-Hydroxyapatite from Snail Shells and Its Biological Activity: Antimicrobial, Antibiofilm, and Biocompatibility. Membranes, 12(4), 408. https://doi.org/10.3390/membranes12040408

